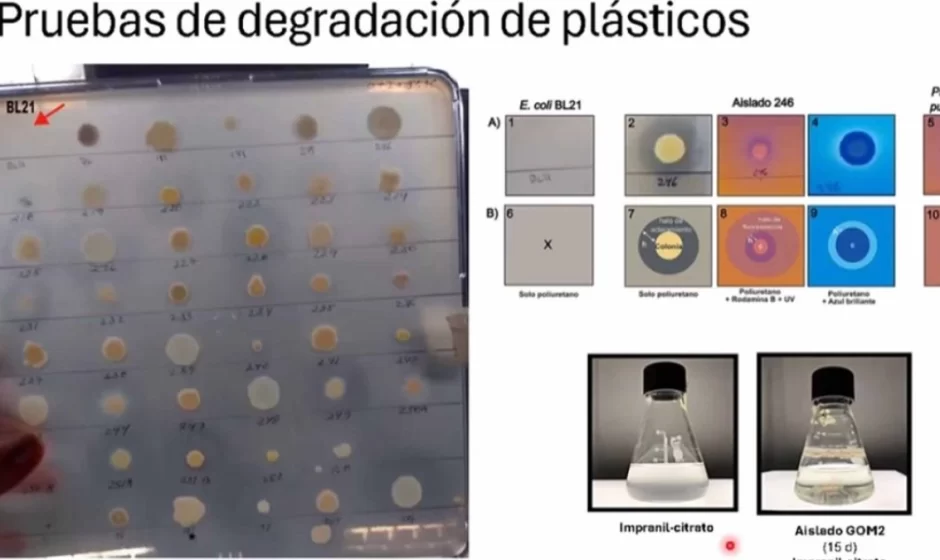

La contaminación por plásticos, uno de los problemas ambientales más graves a escala global, podría encontrar una alternativa biotecnológica en un hallazgo realizado por investigadoras del Instituto de Biotecnología (IBt) de la Universidad Nacional Autónoma de México (UNAM). Científicas de esta institución identificaron que la bacteria Stutzerimonas frequens, localizada a mil metros de profundidad en el Golfo de México, es capaz de degradar hasta el 30 por ciento del poliuretano en apenas 15 días.
El descubrimiento, encabezado por las investigadoras Liliana Pardo López y Nallely Magaña Montiel, fue dado a conocer en la revista especializada Marine Pollution Bulletin. La cepa, identificada como Stutzerimonas frequens (GOM2), forma parte de una colección de aproximadamente 300 bacterias recolectadas durante campañas oceanográficas realizadas desde 2015 en el Golfo de México.
De acuerdo con la publicación, alrededor del 80 por ciento de las bacterias analizadas mostró alguna capacidad para degradar plásticos, aunque solo una fracción logró actuar sobre tres tipos distintos de materiales sintéticos. Entre ellas, Stutzerimonas frequens destacó por su eficiencia para descomponer poliuretano, uno de los plásticos más persistentes y difíciles de eliminar del ambiente.
El contexto del hallazgo es relevante ante la magnitud del problema. Desde la invención de los plásticos, en la segunda mitad del siglo XX, se han generado más de 8 mil 300 millones de toneladas de residuos a nivel mundial. De ese volumen, apenas el 9 por ciento se recicla, el 12 por ciento se incinera y el 79 por ciento termina acumulado en suelos, océanos y otros cuerpos de agua, según datos recopilados por Marine Pollution Bulletin.
El poliuretano, uno de los plásticos más utilizados, se produce en alrededor de 18 millones de toneladas al año. Sin embargo, solo el 29.7 por ciento se recicla, mientras que el resto permanece como residuo ambiental, incluso en zonas remotas como glaciares de montaña o las profundidades marinas.
Las investigadoras explicaron que el interés en las bacterias del Golfo de México radica en las características únicas de la región, donde existen concentraciones naturales y antropogénicas de hidrocarburos derivadas de la actividad petrolera. Estas condiciones han favorecido la evolución de microorganismos capaces de “alimentarse” de compuestos complejos, lo que les otorga una notable capacidad para degradar materiales como los plásticos.
Para evaluar la eficacia de la cepa, el equipo utilizó análisis fisicoquímicos especializados, como GPC, FTIR y GC-MS, con los que monitorearon la pérdida de peso molecular del polímero, cambios en sus grupos funcionales, la desaparición de precursores tóxicos del poliuretano y la aparición de metabolitos secundarios.
En colaboración con la investigadora Denhi Schnabel, también se realizaron pruebas biológicas con embriones de pez cebra expuestos a los residuos plásticos tras la acción bacteriana. Los resultados mostraron una reducción del 80 por ciento en la tasa de mortalidad, lo que evidencia una disminución significativa de la toxicidad del material degradado.
“Esta cepa revirtió con éxito la letalidad embrionaria del Impranil en el pez cebra mediante la biodegradación del poliuretano, lo que demuestra su potencial para reducir la toxicidad de este plástico”, destaca el estudio.
Nallely Magaña Montiel subrayó que uno de los principales objetivos fue identificar una bacteria capaz de degradar el poliuretano sin generar grandes cantidades de compuestos tóxicos recalcitrantes. Además, entre los subproductos detectados se encontraron sustancias con potencial para el desarrollo de bioplásticos y compuestos con actividad antifúngica o antimicrobiana.
El siguiente paso de la investigación será identificar otras bacterias que puedan degradar los compuestos que Stutzerimonas frequens no logra eliminar por completo. La meta, señalaron las científicas, es crear consorcios microbianos capaces de enfrentar la complejidad de los plásticos comerciales, que contienen colorantes, aditivos y otras sustancias difíciles de descomponer.
A largo plazo, las investigadoras consideran que la solución más eficaz podría ser la combinación de distintos microorganismos especializados. Liliana Pardo López afirmó que el objetivo final es desarrollar aplicaciones comerciales, como “sobres de bacterias”, que puedan ser utilizados por los consumidores para reducir el impacto ambiental de los residuos plásticos.